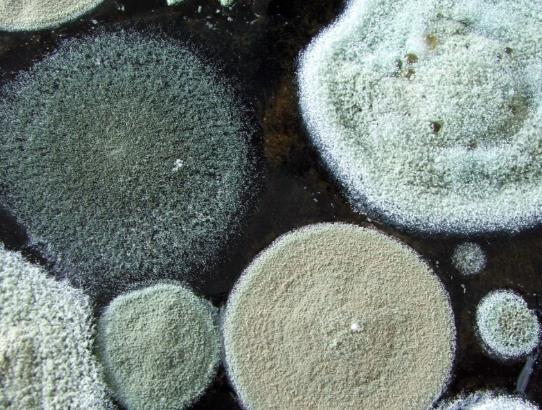

https://smartstore.naver.com/365saless/products/4463263203
쿨쿠리 쿨매트 냉수 아이스 패드 : 365할인샵
쿨쿠리 쿨매트 냉수 아이스 패드
smartstore.naver.com

잇님덜(❀╹◡╹) 안녕하세요!



날씨가 매우 화창한데요. 주말 내내
제가 사는곳은 하루종일 비가 와서
집안이 완전 눅눅하고 얼마나 습한지
빨래를 건조하는데도 젖은 것이
마르지 않아서 집안에 덜마른 빨래로
냄새가 온통 베겨있었네요ㅠㅠ 그래서
그런지 작년에 사놓았던 제 겔타입에
쿨매트가 글쎄 곰팡이가 핀거 있죠. 우이..
저는 솔직히 쿨매트 곰팡이가 생길거라
생각을 못했는데 이렇게 막상 생기니깐
굉장히 당황스럽기도 하고 이제 곧
여름도 다가오는데 어떻게 해야할까
심히 고민중인데요.



그 뿐만 아니라 겔타입이 애초에 만들어
질때부터 수분기가 가득하기 때문에
더 쿨매트 곰팡이가 잘 생기지 않나
생각이 들어요. 그래서 곰팡이 제거하기
위해서 별짓을 다 해봤는데요. 정말
소용없는 짓인거 있죠. 집안에 왁스를
가지고 없애려다가 괜히 얇아진 겉면에
찢어지는 바람에 겔이 밖으로 다 세어나와서
결국엔 쓰레기통 행으로 향하게 되었네요.

정말 곰팡이 생기지 않는 쿨매트는
어디 없는건가욧? 쿨매트는 원래
다 이렇게 생기는 건가요? 라고
생각하면서 다시는 사지 말아야지
하고 마음을 다짐하는데도

작년에는 정말 어마어마하게
잘 사용했던 기억이 있어서 이번 년도에도
포기할수가 없는거 있죠. 그래서 이번에
새제품으로 해서 이번에는 곰팡이도
잘 생기지 않으면서 좋은거 어디없나 알아봤는데요.
글쎄 완전 괜찮은 물건 발견했지뭐에요.
바로 365할인샵이라고 해서
일명 쿨쿠리 쿨매트라고 하던데
이건 냉수를 직접적으로 넣어서
사용하는거라 그런지 원하는 만큼
물을 넣을 수 있는것은 물론이고



물을 넣어서 혹시나 터지더라도 문제가
없을거라 생각이 들었죠. 또 하나
좋은점은 얼마전에 다들 뉴스 보셨나요?
요즘에 라돈 때문에 다시 한번 파동이
일어났는데요. 그 거 때문에 함부러
매트리스나 패드 사용하는게 꺼려지는
반면에 이건 인체에 해롭지 않은선에
안전수치기준을 모두 통과해서 그런지
믿고 사용할 수 있겠다 싶었어요.

또한 요즘에는 모직이라고해서 혹은
기능성이라고해서 안전수치에 대해서 정확한
기제가 되지 않아있는데 이건 자세히
등재되어있다 보니 더 안심해서 사용할 수
있겠다란 생각이 들어서 하나
마련하게 되었는데요.



굉장히 배송도 빠르고 물건도 포장이
꼼꼼하게 상자에 한번 비닐에 한번
더 포장이 된 상태로 평일 기준 이틀 안으로
물건을 받을 수 있었는데요. 상자가
생각보다 커서 저는 당연히 무거울 줄
알았는데 엄청 가볍더라구요. 특히나
전에 사용했던 쿨매트를 생각하면
꽤나 무거웠던걸로 기억하거든요.
근데 이건 물을 넣어서 사용하는거라
그렇게 무겁게 만들어진게 아닌것 같아요.



안을 개봉하게 되면 설명서와 함께
물건이 들어있는데요. 선택지에 싱글을
주문하면 방석 한개와 베개 하나가 추가로
더블을 사면 베개 두개와 방석 두개 이런식으로
보내지고 있어요. 크고 넓게 사용하는 분은
더블 혼자 간단하게 사용하실거면 싱글이
좋을것 같아요. 상세한 사이즈는 이미
나와있으니 확인하고 사는것도 좋은 선택지가
될듯 하네요^^


그렇다면 설명서부터 둘러볼게요.
설명서에는 쿨쿠리에 대한 장점이 나와있고
다음으로는 사용하는 방법이 나와있어요.
그리고 그 밑으로 구성품에 대한
사이즈가 표기되어있고 그 밑으로
고객전화 번호가 있어서 문제가 있을시
연락하면 될듯 싶어요.



쿨매트에 오염이 생기지 않는다는
가장 큰 원인은 물을 제거해서 건조해서
보관하는것이지만 또하나의 이유는
원단 자체에 있다고 하는데요. 이게
그냥 봤을 경우에는 인견 느낌이 들지만
아문젠 기법으로 모직의 종류 중 하나라해요.
그래서 통기성이 좋고 더 촉감도 부드럽고
거기에 튜브 재질 비슷하게 만들어져
미리 방지하는데 효과적이라고 할
수 있다고 하는것이죠.



그럼 아까 설명서에 따라서 사용해보도록
하겠습니당! 일단 가장 먼저 뚜껑을
오픈해주면 되는데요. 가장 자리 쪽을
보시면 동그랗게 플라스틱으로 되어있는 부분이
눈에 띄실거에요. 그걸오른쪽으로 돌면
닫아주고 왼쪽으로 돌리면 열린답니다.
그렇게 왼쪽으로 돌려서 오픈하면
안에 한번 더 막혀있는데 보이시는데
이 부분을 위로 올려서 뽑아준다는 느낌으로
열어주시면 속이 뻥! 뚫려있어요.



거기에 함께 도봉되어있던 깔대기를
사용해서 꽂아주면 되는데요.
꽂은 후에 물을 넣어주시면 간단하게
넣을 수 있어요. 그런데 저는 생각보다
물이 많이 들어간것 같은 기분이 들어서
그러는데 이용하시는 잇님이 있다면
꼭 화장실에서 물을 넣는것을 권할게요.



물은 너무 많지 않고 살짝 시원함을
느낄 정도만 넣고 혹시나 함께 들어간
공기가 너무 많다고 느껴지시면
손바닥을 이용해서 공기를 제거하도록
해주세요. 아까 열어준 반대로
닫아줄거에요. 그러면 쿨매트 사용하기에
완성이 되었는데요.


그럼 사용할 침구 위에 올려놓아주고
예쁘게 셋팅해봅시다. 그런 후에
올라가서 누워봤는데요. 역시나 작년에
사용했었던 쿨매트와 다름없이
시원하더라고요. 특히나 이 시원함이
겔이나 젤에 비해서 무려 2배 이상 시원함이
지속된다고 하는데요.

그 이유가 안에 들어있던 3D라는
입체매쉬 때문이라고해요. 매쉬가 공기
통풍에 효과적인데 바람이 불어오면
매쉬를 통해서 따뜻한 공기를 식혀서
순환하기 때문에 열기를 빨아드리는
물이 차갑게 변한다고 하더라고요.
그렇다보니 더 오랫동안 시원함을 지속할
수 있는것이죠. 그리고 한곳에 누운것보다
좀 미지근했다 싶으면 다른 부분에
누워주시면 처음 느낀 시원함을 그대로
느낄 수 있답니다. 다들 사용하실거면
쿨매트 곰팡이 나는거 말고 365할인샵꺼
사용해보시는것을 권해드릴게용!
https://smartstore.naver.com/365saless/products/4463263203
쿨쿠리 쿨매트 냉수 아이스 패드 : 365할인샵
쿨쿠리 쿨매트 냉수 아이스 패드
smartstore.naver.com

'diary' 카테고리의 다른 글
| 푸쉬업바 집중적인 근육만들기 (3) | 2019.12.30 |
|---|---|
| 탄소매트 단점 찾기?! (3) | 2019.11.11 |
| 마카오 vip 에이전시 통해 편하게 누리고왔어요! (0) | 2019.05.29 |
| 트위터 동영상 저장 쉽게하는법 (2) | 2019.02.26 |
| 휘인 아버지 :: 그녀는 비난받을 이유가 없다. (0) | 2018.11.29 |